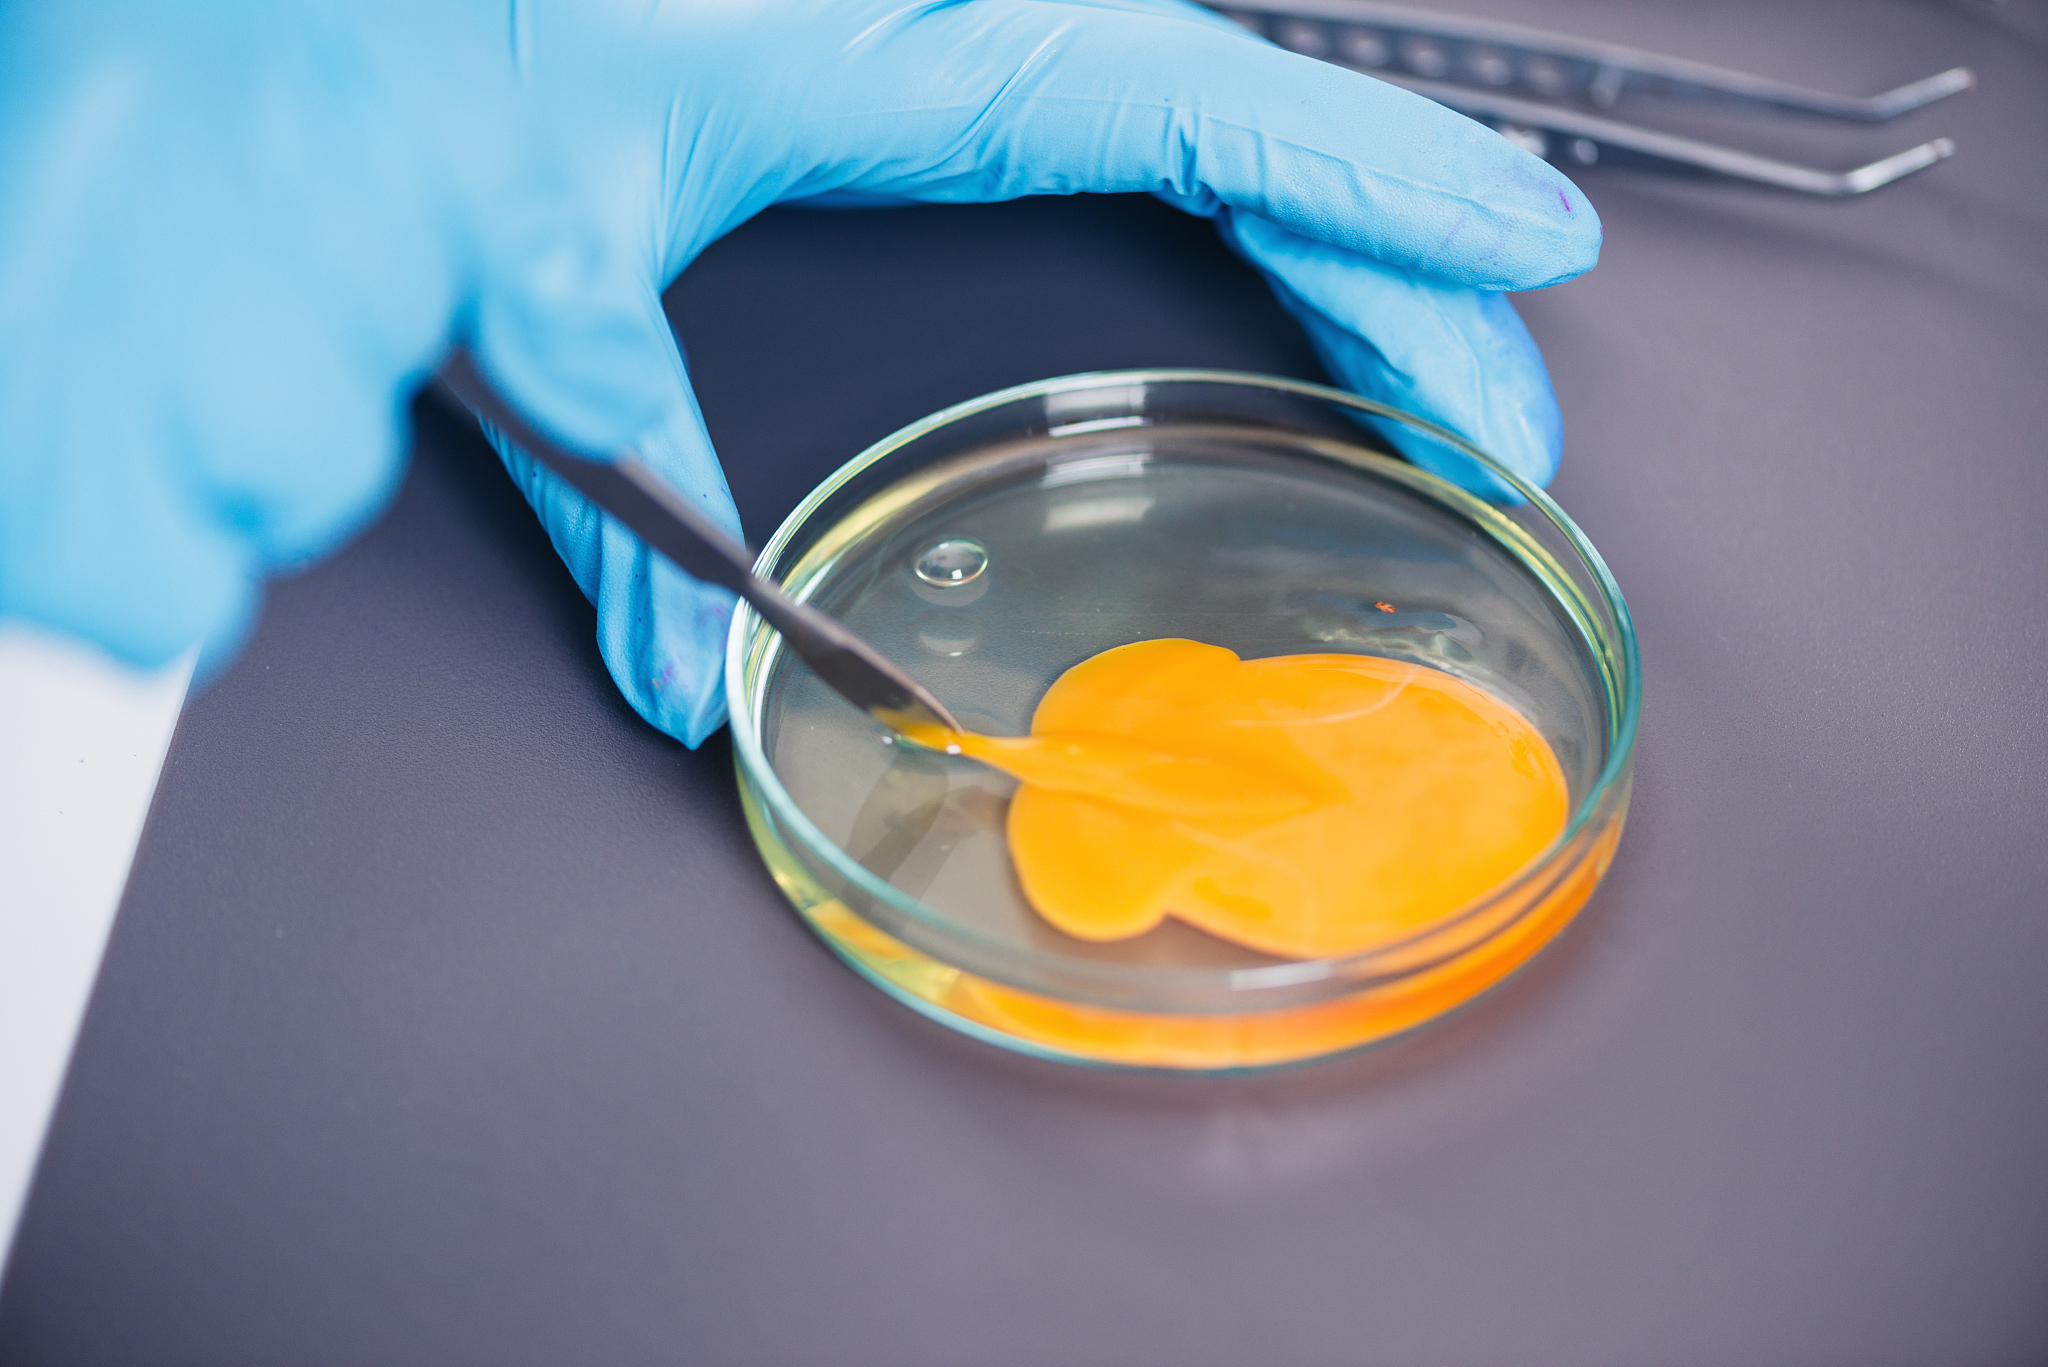
冻胚移植后吃黄豆？科学饮食指南助您顺利好孕

冻胚移植后吃黄豆?科学饮食指南助您顺利好孕
- 冻胚移植后如何科学饮食:黄豆是否适宜?
- 黄豆的营养价值及其在冻胚移植后的饮食中的应用
- 冻胚移植后的饮食禁忌与建议:是否可以食用黄豆?
- 冻胚移植后如何合理安排饮食:黄豆是否有利于受孕?
- 黄豆对冻胚移植后的影响及其在饮食中的正确食用方式
- 冻胚移植后的饮食策略:是否可以吃黄豆来促进受孕?
- 黄豆是否适合冻胚移植后的饮食:营养师的解答
- 冻胚移植后的营养需求与饮食建议:黄豆是否有必要?
原文地址: https://www.cveoy.top/t/topic/mP0S 著作权归作者所有。请勿转载和采集!